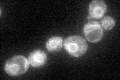
YIL043C
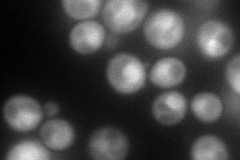
YIL043C
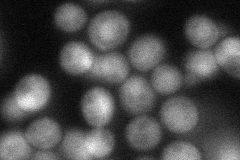
YIL043C
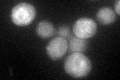
YIL043C

View description
Microsomal cytochrome b reductase, not essential for viability; also detected in mitochondria; mutation in conserved NADH binding domain of the human ortholog results in type I methemoglobinemia
Localization:
Intensity:
Fold change:
Significance:
-
C’ GFP library in SD
ER41.73 -
N' NOP1pr-GFP in SD
cytosol,nucleus178.106 -
N' TEF2pr-mCherry in SD

cytosol,nucleus138.434 -
N' NATIVEpr-GFP in SD
cytosol,nucleus63.2068 -
N' TEF2pr-VC and Cyto-VN in SD

missing0 -
C’ GFP library in SD+DTT
ER37.10.88No -
C’ GFP library in SD+H2O2

ER39.970.95No -
C’ GFP library in Starvation Media

ER36.260.86No -
C’ GFP library on the background of Pup2-DaMP

ER -
C’ GFP library on the background of CCT mutant

ER41.67170.998169No
